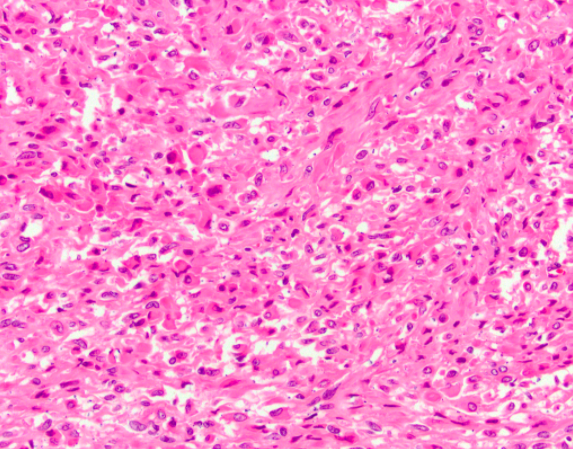

Case History
Q.1. 46 y/F underwent TAH BSO for AUB. A 5 cm myometrial nodule was identified on gross examination.
What is the diagnosis?
- FH deficient leiomyoma
- Epithelioid leiomyoma
- PEComa
- Leimoyoma with degen change

Answer: PEComa (Perivascular epithelioid cell tumor)
Although Perivascular epithelioid cell tumors (PEComas) are uncommon, they need to be kept in the differential diagnosis of myometrial tumors especially those demonstrating epithelioid features. Uterine PEComas are usually sporadic but association with tuberous sclerosis is seen in a subset of cases. The tumor here displays epithelioid and spindle cells with eosinophilic cytoplasm and mildly pleomophic nuclei with some showing prominent nucleoli. They express both smooth muscle (SMA, desmin and h-caldesmon) and melanocytic markers (HMB45, Melan-A). Malignant PEComas are diagnosed based on a set of criteria that include size > 5 cm, infiltrative pattern, high nuclear grade, mitotic count >1/50 mm2, necrosis and vascular invasion.
The other differential diagnoses to be considered are leiomyomas as they are the most common benign uterine tumors. Leiomyomas can also show prominent epithelioid features. Leiomyomas with bizarre nuclei show nuclear atypia and low mitotic count. A subset of these are FH deficient and characteristically show alveolar type edema, staghorn blood vessels and prominent eosinophilic nucleoli. Rhabdoid/skeletal muscle changes have been described in leiomyomas. IHC are helpful as these rhabdoid cells stain positive for smooth muscle markers despite their appearance. When faced with an epithelioid myometrial tumor, PEComa should be considered in the differential diagnosis.
References:
-
- Fadare O. Perivascular epithelioid cell tumor (PEComa) of the uterus: an outcome-based clinicopathologic analysis of 41 reported cases. Adv Anat Pathol. 2008 Mar;15(2):63-75. doi: 10.1097/PAP.0b013e31816613b0. PMID: 18418088
- Perivascular epithelioid cell neoplasm (PEComa) of the gynecologic tract: clinicopathologic and immunohistochemical characterization of 16 cases
- Parker RL, Young RH, Clement PB. Skeletal muscle-like and rhabdoid cells in uterine leiomyomas. Int J Gynecol Pathol. 2005 Oct;24(4):319-25. doi: 10.1097/01.pgp.0000177647.45890.b5. PMID: 16175075.
- Leiomyoma with bizarre nuclei: a morphological, immunohistochemical and molecular analysis of 31 cases